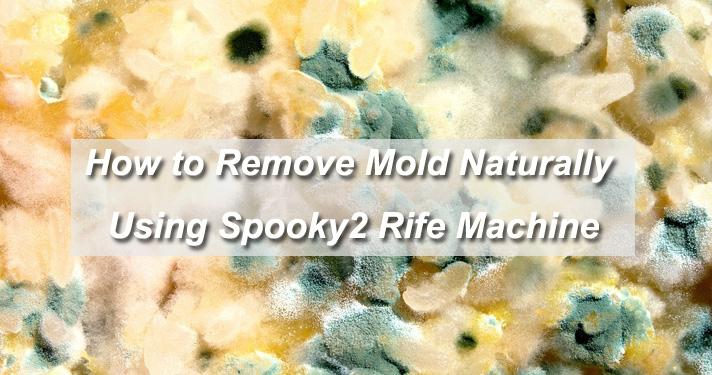

Czy widziałeś czarną pleśń w domu w kuchni lub w pralni? Czy mieszkasz w piwnicy z czarną pleśnią? A może mieszkasz w pobliżu morze lub w wilgotnym środowisku? Czy twój pracujący budynek jest kiedykolwiek zalany? Jeśli masz którekolwiek z tych doświadczeń, możesz mieć chorobę czarnej pleśni. W dzisiejszych czasach wiele osób umiera z powodu choroby czarnej pleśni, ale nie wiedząc o tym.

Prawda o czarnej pleśni
Czarna pleśń może powodować różne rodzaje chorób, w tym ból gardła, nudności, wymioty, wypadanie włosów i tak dalej. Jeśli będziesz zbyt długo narażony na czarną pleśń, możesz umrzeć z tego powodu.
Usuwanie pleśni za pomocą Spooky2 maszyny Rife
Jedną które ludzie wybierają, aby pozbyć się pleśni zarówno w części mieszkalnej, jak i w ciele, jest teraz użycie maszyny Rife. Jeśli jesteś nowym użytkownikiem, kliknij tutaj.
Spooky2 pomoże ci nie tylko usunąć pleśń w domu, ale także te w twoim ciele i zmniejszyć objawy spowodowane przez pleśń.
Istnieją 2 sposoby na pozbycie się pleśni w Spooky2:
Tryb zdalny i tryb plazmowy
Tryb zdalny:
Aby było bardziej jasne, cały proces można postrzegać jako dwie części.
Część 1: Zabij pleśń w swoim domu.
Część 2: Pomóż swojemu ciału w walce z chorobami pleśni i ich objawami.

Część 1 Dane szczegółowe
Sprzęt:
Znajdź czarną pleśń w swoim domu, przetrzyj ją papierową taśmą maskującą i włóż do Spooky2 Remote v2.0, aby zabić zarodniki pleśni w twoim środowisku mieszkalnym, piwnicy, samochodzie itp.Podłącz Remote v2.0 do swojego generatora. (Jeśli nie wiesz jak, sprawdź tutaj)
Oprogramowanie:
Uruchom oprogramowanie Spooky2, przejdź do zakładki Presets, kliknij>Environmental >Remote i wybierz potrzebne preset zgodnie z Notes po prawej stronie.

Teraz przejdź do zakładki Control, zaznacz pole Overwrite Generator, a następnie kliknij różowy / czerwony przycisk generatora. Kliknij przycisk Start, aby uruchomić preset. Uruchom go bez przerwy, aż się uda.
Część 2 Dane szczegółowe:
Sprzęt:
Podłącz trzy remote v2.0 do trzech generatorów.
Użyj paznokcia jako próbki DNA, wytnij trzy kawałki paznokcia i umieść po jednym w każdym z remotów Spooky2 v2.0.
Oprogramowanie:
Generator A: Zabij pleśnie w swoim ciele
Przejdź do zakładki Presets, kliknij> Shell (Empty) Presets> Remote> Killing (R) - JW
Następnie przejdź do zakładki Programs, wyszukaj „mold” i wybierz odpowiednie programy zgodnie z opisem programu.Teraz przejdź do zakładki Control, zaznacz pole Overwrite Generator, a następnie kliknij różowy / czerwony przycisk generatora.
Generator B: Pomoc w objawach spowodowanych przez pleśń
Przejdź do zakładki Presets, kliknij> Shell (Empty) Presets> Remote> Healing (R) - JW
Zobacz listę objawów choroby pleśni. Wyszukaj w bazie danych Spooky2 odpowiednie programy leczenia w zakładce Programs.
Oto niektóre z programów symptomów, które ludzie wybierają z bazy danych Spooky2 leczącej choroby pleśni:
Ból / chrypka w gardle
Objawy przeziębienia i grypy (bóle głowy, lekka gorączka i bóle mięśni)
Krwotok z nosaMrowienie lub pieczenie nosa, ust i potu (pod pachami lub między nogami)
Chroniczne zmęczenie
Zawroty głowyNudności wymioty
Utrata pamięci
Problemy z deficytem / koncentracją
Zmiany osobowości, takie jak drażliwość lub depresja
Zaburzenia neurologiczne, takie jak drżenia
Wypadanie włosów
Kaszel z krwią
Krwawienie w płucach (hemosyderoza)
Uszkodzenie narządów wewnętrznych, w tym krwi, wątroby, nerek i płuc
Teraz przejdź do zakładki Control, zaznacz pole Overwrite Generator, a następnie kliknij różowy / czerwony przycisk generatora.Uruchom te programy w sposób ciągły za pomocą Spooky2 Remote v2.0, aż objawy ustąpią.
Generator C: Detox
Przejdź do zakładki Presets, kliknij >Detox >Remote, wybierz wymagany preset zgodnie z uwagami (Jeśli nie wiesz, który wybrać, Detox Maintenance (R) - JK jest zalecany ).

Teraz przejdź do zakładki Control, zaznacz pole Overwrite Generator, a następnie kliknij różowy/czerwony przycisk generatora, aby uruchomić detox preset.
Tryb plazmy:

Preset: Mold and Slime 2 Day Home Treatment (P) – JW (pod >Environmental >Plasma > katologu)
Czas: Dwa dni każdej sesji. Uruchomić do momentu, aż pleśń zniknie.

Uwagi:
- Zalecamy opuszczenie pokoju po usunięciu pleśni w domu (część 1).
- Kiedy otrzymasz próbkę, noś maskę przeciwpyłową, aby uniknąć wdychania zarodników.
- Potrzebujesz 3 generatorów dla części 2, jednego do zabijania pleśni w środku, jednego do leczenia objawów spowodowanych pleśnią, a trzeciegoiego do detoksykacji. Jeśli masz tylko dwa generatory, możesz utworzyć dwa presety w Generatorze A i Generatorze B w łańcuch preset(ang. preset chain).
- Możesz również wziąć kąpiel stóp w tym samym czasie, aby pomóc oczyścić swoje ciało.
- Nasze oprogramowanie jest ciągle aktualizowane, możesz użyć powyższego preset, aby zastąpić „8-godzinne sweeps” wspomniane przez Jeffa w trybie plazmy.
Specjalne podziękowania za wsparcie od Chaffee Cline i Jeff Kaczor.